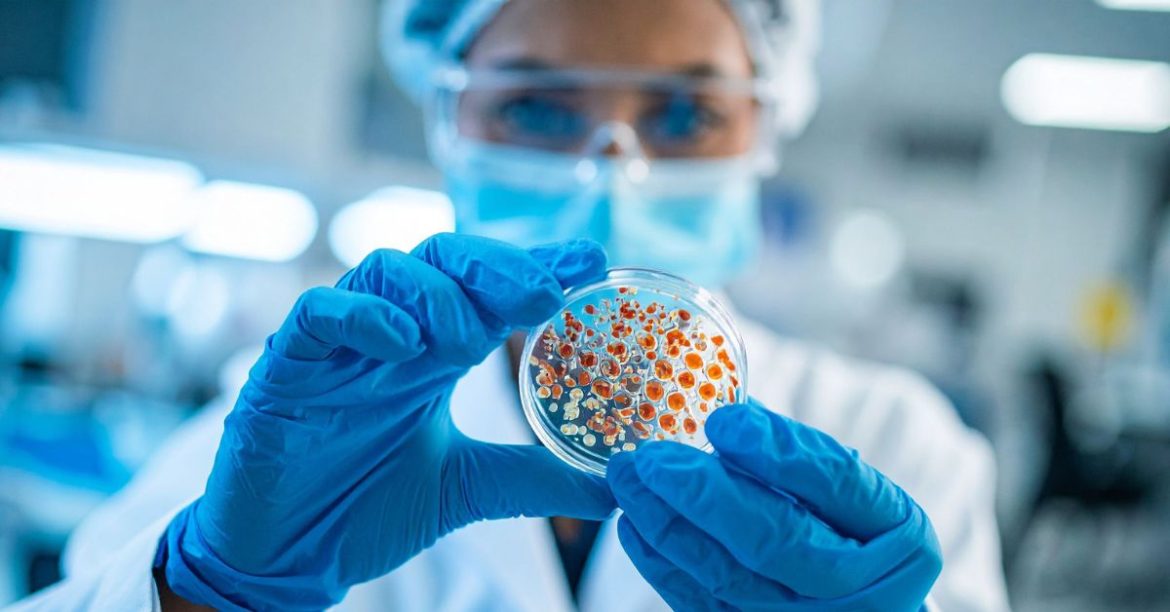

Κοτόπουλο και σαλμονέλα. Δύο λέξεις που, καλώς ή κακώς, πάνε μαζί – και καλό είναι να τις έχουμε πάντα στο μυαλό μας όταν μαγειρεύουμε πουλερικά. Πολλοί αναρωτιούνται «πώς φαίνεται η σαλμονέλα στο κοτόπουλο» ή αν μπορεί να αναγνωριστεί με το μάτι. Η αλήθεια είναι πως τα βακτήρια της σαλμονέλας δεν φαίνονται — δεν αλλάζουν απαραίτητα το χρώμα, τη μυρωδιά ή την υφή του κρέατος. Γι’ αυτό είναι κρίσιμο να γνωρίζουμε πώς να προφυλασσόμαστε από τη μόλυνση από τη στιγμή της αγοράς μέχρι το πιάτο μας.
Το κοτόπουλο είναι από τις πιο συχνές επιλογές στο εβδομαδιαίο μας μενού, καθώς θεωρείται υγιεινή και ελαφριά πηγή πρωτεΐνης. Όμως, ανήκει και στις πιο ευαίσθητες κατηγορίες τροφίμων σε ό,τι αφορά τη μικροβιακή αλλοίωση, και η ελλιπής προετοιμασία του μπορεί να κρύβει σοβαρούς κινδύνους για την υγεία.
Το καλό νέο; Με σωστούς χειρισμούς, μπορούμε να απολαύσουμε το κοτόπουλό μας χωρίς ανησυχία. Δες παρακάτω τι να προσέξεις από τη στιγμή της αγοράς μέχρι το πιάτο.
Αγοράζοντας πουλερικά
-
Ελέγξε προσεκτικά την ημερομηνία λήξης της συσκευασίας.
-
Πιάσε τη συσκευασία ώστε να διαπιστώσεις ότι το περιεχόμενο διατηρείται ψυχρό.
-
Κράτησέ το μακριά από λαχανικά και φρούτα κατά την αγορά.
Αποθηκεύοντας πουλερικά
-
Βάλε τα στο πιο ψυχρό μέρος του ψυγείου (0–4°C).
-
Φύλαξέ τα μακριά από ωμά φρούτα και λαχανικά, σε ξεχωριστό σημείο και καλά τυλιγμένα ώστε οι χυμοί τους να μην στάξουν σε άλλες τροφές.
-
Αν δεν προλαβαίνεις να τα μαγειρέψεις πριν την ημερομηνία λήξης, κατάψυξέ τα κάτω από –18°C. Σημείωσε την ημερομηνία φύλαξης και κατανάλωσέ τα μέσα στους επόμενους 9 μήνες.
-
Ωμά πουλερικά χωρίς ημερομηνία λήξης πρέπει να καταψύχονται αν δεν μαγειρευτούν μέσα σε 2–3 ημέρες (ή μέσα σε 24 ώρες αν είναι τεμαχισμένα).
-
Κατανάλωσε μαγειρεμένα πουλερικά το πολύ μέσα σε 3–4 μέρες ή αλλιώς κατάψυξέ τα.
Μαγειρεύοντας πουλερικά
-
Απόψυξέ τα στο ψυγείο ή στο φούρνο μικροκυμάτων.
-
Μην αφήνεις ωμά πουλερικά εκτός ψυγείου πάνω από 1 ώρα.
-
Απόφυγε το πλύσιμό τους (ή αν τα πλύνεις, καθάρισε σχολαστικά τον πάγκο και τις επιφάνειες, γιατί οι σταγόνες εξαπλώνουν βακτήρια).
-
Πλύνε καλά τα χέρια σου για τουλάχιστον 20 δευτερόλεπτα πριν και μετά την επαφή με ωμό κοτόπουλο.
-
Χρησιμοποίησε ξεχωριστό ξύλο κοπής και μαχαίρι για ωμά πουλερικά και διαφορετικά για φρούτα ή λαχανικά. Καθάρισε σχολαστικά εργαλεία και πάγκο μετά τη χρήση.
-
Κατά το μαγείρεμα, χρησιμοποίησε θερμόμετρο: το κρέας πρέπει να φτάσει τουλάχιστον τους 75°C στο κέντρο για 1 λεπτό.
Το καλοκαίρι, οι υψηλές θερμοκρασίες ευνοούν την ανάπτυξη παθογόνων μικροοργανισμών. Γι’ αυτό κράτα τις παραπάνω οδηγίες στο μυαλό σου για να αποφύγεις δυσάρεστες καταστάσεις!
🥼 Σημαντικό να θυμάσαι
-
Δεν υπάρχει τρόπος να δεις τη σαλμονέλα με το μάτι. Το κοτόπουλο μπορεί να φαίνεται φυσιολογικό αλλά να είναι μολυσμένο.
-
Η πρόληψη είναι το κλειδί: σωστή ψύξη, προσεκτικός χειρισμός, και επαρκές ψήσιμο στους 75°C.
📌 Το άρθρο συντάχθηκε από την Κυριακή Ζακχαίου, διατροφολόγο – βιοχημικό και ιδιοκτήτρια του www.diatrofisimera.gr.
🌐 Social Media:
Instagram | TikTok | Facebook | YouTube
🙏 Σας ευχαριστώ που με εμπιστεύεστε για τη διατροφή σας!

18 σχόλια
hi:)polu xrisimes plirofories!i alithia einai oti den iksera poso epikindino einai to kotopoulaki…..kai xthes ekana kati pou mallon einai lathos……ebrasa kateythian to kotopoulo xwris na to ksepagwsw……einai epikindino i oxi??????
Καλησπέρα, δεν είναι απαραίτητα επικίνδυνο, αν η θερμοκρασία ανέβηκε στους 100 βαθμούς Κελσίου για 1 λεπτό ακόμη και στο πιο βαθύ σημείο του κρέατος τότε δεν υπάρχει πρόβλημα. Το πρόβλημα με τα παγωμένα κρέατα που βάζουμε κατευθείαν στο φούρνο δημιουργείται διότι το κρέας ξεπαγώνει απ’έξω γρήγορα, ψήνεται και ροδίζει δίνοντάς μας την εντύπωση ότι έχει ψηθεί και εσωτερικά, ενώ στην πραγματικότητα δεν έχει προλάβει να ανεβάσει τους 100 βαθμούς στο εσωτερικό του (πολλές φορές όχι μόνο δεν έχει ψηθεί αλλά παραμένει και τελείως ωμό) και άρα δεν έχει εξοντωθεί το βακτηρίδιο της Σαλμονέλας. Ευχαριστώ.
Πρέπει να γνωρίζουμε πως πρέπει να τοποθετούμε τα τρόφιμα στο ψυγείο μας και σε τι θερμοκρασία για να συντηρούνται σωστά. Το κρέας πρέπει να ξεπαγώνει περίπου στις 6 ώρες πριν το μαγειρέψουμε.
Έτσι είναι, ευχαριστώ για το σχόλιο!
ekopsa mia petsa apo kotopoulo pou molis eixa agorash gia na kopso to kotopolo sta 2 alla mono mia petsa ekopsa meta apo kamia wra afeirimenh ekopsa pswmi me to idio maxai ri kai to aloipsa me lavas meta traviksa oti eixe meinei apo to maxairi kai to efaga meta to thimithika ti eixa kanei kai pira ena amoxil bas kai prolavo mhn pathw kamia salmonella lete na epatha poso pithanon einai?
Καλημέρα! Η μόλυνση των πουλερικών με σαλμονέλα δεν είναι κανόνας αν και υπάρχουν αυξημένες πιθανότητες – ιδιαίτερα αυτή την εποχή! Εύχομαι να μην πάθατε τίποτα τελικά!
η σαλμονελα αναπτυσεται απο κακη συντηρηση της τροφης?δηλ αν αλλοιωθει ενα κοτοπουλο που εμεινε εκτος ψυγειου αναπτυσεισαλμονελα? η προυπαρχει σε συγκεκριμενα κοτοπουλα ουτως η αλλως?
Ένα τρόφιμο επιμολύνεται με σαλμονέλα όταν έρθει σε επαφή με τα βακτηρίδια της σαλμονέλας που υπάρχουν στα περιττώματα των ανθρώπων και των ζώων. Το μολυσμένο τρόφιμο αν διατηρηθεί στις σωστές θερμοκρασίες τότε η μόλυνσή του κρατιέται σε περιορισμένο βαθμό και εξαλείφεται με το σωστό μαγείρεμα – με τον τρόπο αυτό γίνεται κατάλληλο για κατανάλωση!
αν φαει καποιος ψητο κοτοπουλο που ομως ηταν ψηλοομω και ειχε λιγο αιμα μπορει να παθει σαλμονελα ?
Γεια σας, ευχαριστώ για το σχόλιο. Ναι, είναι πιθανό να πάθουμε σαλμονέλα αν το κρέας είναι εξαρχής μολυσμένο, κάτι όμως που δεν έχουμε την δυνατότητα να γνωρίζουμε εκ των προτέρων. Γι’αυτό είναι σημαντικό να ψωνίζουμε φρέσκο και ποιοτικό κρέας από καλή πηγή, να το αποθηκεύουμε σωστά και να το ψήνουμε επαρκώς όπως αναφέρεται στο άρθρο.
Καλησπέρα
Σήμερα το μεσημέρι γυρνώντας απ’ το σχολείο, γύρισα πεινασμένος και καθώς όλοι έλειπαν λόγω κάποιων δουλειών, έβαλα φαγητό μόνος μου. Το πρόβλημα είναι ότι τρώγοντας διαπίστωσα πως το κοτόπουλο είχε αίματα σε πολλά σημεία. Επειδή η αδερφή μου που είναι λίγο πρωτάρα στα κουζινικά το μαγείρεψε, φαίνεται πως δεν το έψησε σωστά.
Το κοτόπουλο αυτό ήταν μαριναρισμένο και κανονικά για σούβλα, αν δεν κάνω λάθος. Σε κάποια σημεία φαινόταν ψημένο, αλλά σε κάποια άλλα είχε πολύ αίμα…
Και εγώ πεινασμένος έφαγα αρκετά σημεία με αίμα, όταν το κατάλαβα, άναψα το φούρνο για 10 λεπτά ακόμη και κατόπιν έφαγα λίγο ακόμα, αλλά πάλι υπήρχαν αίματα.
Μη τα πολυλογώ το κοτόπολου δεν ήταν σε όλες τις μεριές καλά ψημένο και έτσι αναγκάστηκα -κακώς βέβαια- να φάω και άψητα μέρη αφαιρώντας τα αίματα.
ΜΕ συγχωρείτε που σας κούρασα αλλά θα ήθελα τι συμβουλή σας για τις συνέπειες των παραπάνω, καθώς με έπιασε αγωνία για το αν θα κολλήσω τίποτα και σαφώς δεν πρόκειται να κάνω πάλι τέτοια απερισκεψία σε τέτοια περίπτωση.
Καλησπέρα σας, δεν είναι δεδομένο ότι κανείς θα νοσήσει αν φάει μερικώς άψητο κοτόπουλο, οι πιθανότητες όμως είναι πολλές. Καλό είναι να προμηθευτείτε ένα θερμόμετρο ώστε να είστε σίγουροι ότι μαγειρέψατε επαρκώς το κρέας. Σε περίπτωση που έχει μαγειρευτεί ανεπαρκώς τότε θα πρέπει να το ξαναμαγειρέψετε μέχρι να είναι σωστά ψημένο μέχρι το κόκκαλο! Εύχομαι να πήγαν όλα καλά!
Χθες πηρα πακετο απο μεξικανικο εστιατοριο κοτοπουλο ψημενο με λαχανικα.δεν το εβαλα στο ψυγειο ομως το βραδυ απλα το ειχα στο ταπερ του στο τραπεζι.μπορω να το φαω η ειναι επικινδυνο?
Γεια σας, ευχαριστώ πολύ για το σχόλιο. Υπάρχει περίπτωση να μην έχει αλλοιωθεί, αλλά αυτό εξαρτάται από πολλούς παράγοντες οι οποίοι είναι αστάθμητοι. Το καλύτερο είναι να περιμένουμε να κρυώσει το φαγητό και μετά να το βάζουμε στο ψυγείο.
Γεια σας. Μπορει καποιος να κολλησει σαλμονελα αν πιασει αυγο και δεν πλενει τα χερια του? Εχω παθει φοβια απο αρθρα που διαβασα παλιοτερα για την σαλμονελα και εφτασα να φοβαμαι να εχω τροφιμα διπλα στο ταπερ που βαζω τα αυγα στο ψυγειο η να απολυμαινω ακομη και το χερουλι της βρυσης αφου την ανοιξω ενω εσπασα αυγο. Η ακομη οταν εχω συσκευασια με κοτοπουλο φοβαμαι που την βαζω στο ψυγειο η που την ακουμπαω στον παγκο της κουζινας και μετα απολυμαινω οτι ακουμπησε. Ποσο ευκολα κολλαει καποιος απο επαφη με τετοια τροφιμα με τα χερια η αν ακουμπησουν καπου στον χωρο?? Μολυνεται οτι ακουμπησουν??
Γεια σας. Τα αυγά που αγοράζουμε συσκευασμένα είναι καθαρά από ακαθαρσίες και συνήθως προέρχονται από υγιείς κότες άρα το πιο πιθανό είναι ότι δεν είναι επιμοσυσμένα με σαλμονέλα. Καλό είναι να φυλάτε τα ωμά αυγά στην συσκευασία τους όπου έτσι προστατεύονται τα γύρω τρόφιμα και το ψυγείο από την επιμόλυνση. Επιπλέον, όταν πιάνουμε ωμά αυγά (όπως και ωμά κρέατα), πρέπει να πλένουμε τα χέρια μας όπως και τα σκεύη και τις επιφάνειες στις οποίες ακούμπησαν για να είμαστε σίγουροι ότι δεν θα μολύνουμε τα ωμά τρόφιμα που θα ακουμπήσουν στην συνέχεια εκεί.
Καλησπέρα.. κοτόπουλο ντοπιο κίτρινο,κ το ξεπαγωσα εξω απτο ψυγείο,κ το αφησα απτη στιγμη που το εβγαλα απτη κατάψυξη 6 ωρες κ μετα το εβαλα ψυγείο..να το πεταξω;
Γεια σας! Το κοτόπουλο είναι από τα πιο “ευαίσθητα” τρόφιμα σε μικρόβια όπως η σαλμονέλα. Αν μείνει εκτός ψυγείου για αρκετές ώρες, μπαίνει στη λεγόμενη “επικίνδυνη ζώνη θερμοκρασίας”, όπου τα μικρόβια πολλαπλασιάζονται γρήγορα. Το ότι μετά μπήκε ψυγείο δυστυχώς δεν αναιρεί το πρόβλημα. Για λόγους ασφάλειας, καλύτερα να μην το καταναλώσετε.
Την επόμενη φορά προτιμήστε να το αφήσετε να ξεπαγώσει αργά μέσα στο ψυγείο. Έτσι διατηρείται ασφαλές μέχρι το μαγείρεμα.